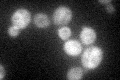
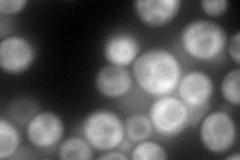
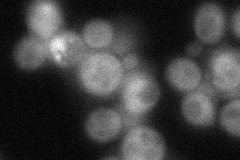
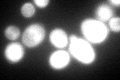
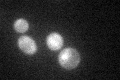

View description
Essential Hsp90p co-chaperone; necessary for passage through the START phase of the cell cycle; stabilizes protein kinase nascent chains and participates along with Hsp90p in their folding
Localization:
Intensity:
Fold change:
Significance:
-
C’ GFP library in SD
cytosol61.69 -
N' NOP1pr-GFP in SD

cytosol140.835 -
N' TEF2pr-mCherry in SD
cytosol215.14 -
N' NATIVEpr-GFP in SD
cytosol54.857 -
N' TEF2pr-VC and Cyto-VN in SD

#N/A0 -
C’ GFP library in SD+DTT
cytosol107.21.73Yes -
C’ GFP library in SD+H2O2

cytosol64.221.04No -
C’ GFP library in Starvation Media
cytosol61.891No -
C’ GFP library on the background of Pup2-DaMP

cytosol -
C’ GFP library on the background of CCT mutant

cytosol74.78311.21213No
